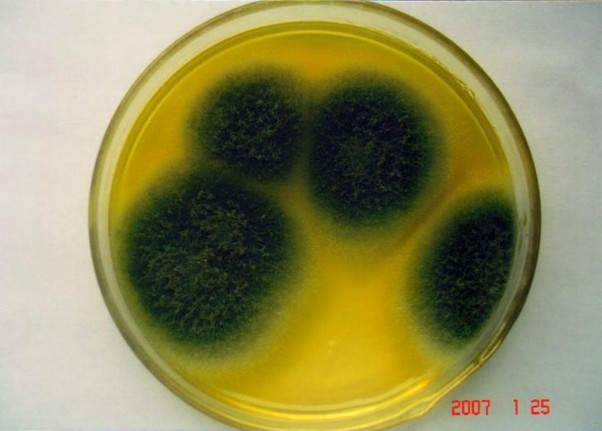
p>烟曲霉(拉丁名为 i>aspergillus fumigatus /i>

烟曲霉m3

烟曲霉
图片尺寸1080x1440
烟曲霉 日常检测要注意血痰,碰见血痰要考虑一下曲霉和结核菌.
图片尺寸1707x1280
图6 烟曲霉镜下图图7 烟曲霉质谱确认图丝状真菌引
图片尺寸423x422
烟曲霉菌顶囊:呈烧瓶形小梗:单层,在顶囊上半部分
图片尺寸1080x809
图5 烟曲霉菌落正面(5天)图6 烟曲霉镜下图图7
图片尺寸456x447
p>烟曲霉(拉丁名为 i>aspergillus fumigatus /i>
图片尺寸602x431
烟曲霉-伟业计量
图片尺寸417x556
烟曲霉
图片尺寸360x219
烟曲霉,常存在于谷物,污染的食品中,是引起人和动物
图片尺寸325x377
烟曲霉菌,生物科技,水平画幅,孢子,微生物学
图片尺寸1200x800
临床微生物笔记分享烟曲霉
图片尺寸1080x1444
曲霉菌ppt
图片尺寸1080x810
干货曲霉辨识心得
图片尺寸613x1280
分享一例烟曲霉镜下
图片尺寸3000x4000
首页 供应信息 化工 化工中间体 > 烟曲霉素 2年
图片尺寸927x680
分享我分离的曲霉菌
图片尺寸480x360
真菌(烟曲霉),扫描电镜
图片尺寸900x1200
分享一例烟曲霉镜下
图片尺寸3000x4000
图1 烟曲霉菌落正面图烟曲霉,常存在于谷物,污染的
图片尺寸342x381
图片由冯长海老师拍摄烟曲霉菌落该曲霉菌落颜色起初
图片尺寸540x541